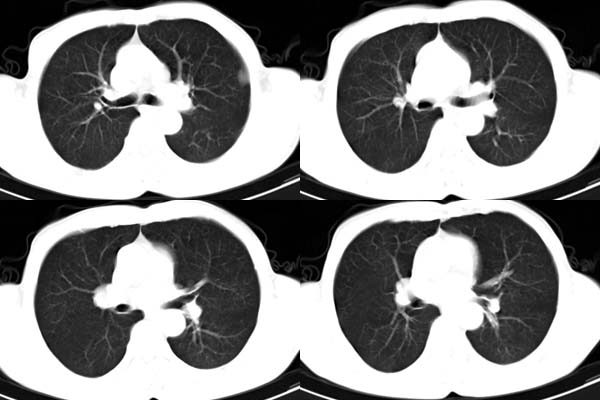

医影在线
标题: CT2380:胸部病变,请讨论 [打印本页]
作者: 过江龙 时间: 2005-12-11 01:07
标题: CT2380:胸部病变,请讨论
患者,男,65岁,咳嗽,胸痛

[本贴已被 gaozhengyi 于 2005-12-10 22:56:45 修改过]
作者: haogandian 时间: 2005-12-11 01:17
胸膜下见多个软组织结节且以宽基底与胸膜相连,上部肋骨似见骨质破坏,考虑:恶性胸膜间皮瘤。
作者: honghuqitian 时间: 2005-12-11 01:30
影像表现不再赘述,支持周围型肺癌,伴胸膜转移。排除胸膜原发肿瘤。
作者: 蜀山精灵 时间: 2005-12-11 02:59
说肺癌纵隔窗上不典型,而胸膜间皮瘤却又没胸水。我觉得胸膜间皮瘤放第一位。
作者: 13081830109 时间: 2005-12-11 03:13
支持周围型肺癌,伴胸膜转移。排除胸膜原发肿瘤
作者: rjg199343 时间: 2005-12-11 03:32
左肺下叶周围型肺癌合并左侧胸膜转移
作者: X线 时间: 2005-12-11 04:00
周围型肺癌并胸膜转移。
作者: lz8320473 时间: 2005-12-11 04:00
ct所见;左下肺可见片状阴影,密度不均,边缘尚清晰,胸膜方向见有条索相连,纵隔窗未见具体结节。左侧胸膜下见多个软组织结节且以宽基底与胸膜相连,右侧胸锁关节层面亦见软组织结节广基与胸膜相连。纵隔未见肿大淋巴结,气管,支气管开口正常。
影象;1,左下肺感染性病变,结核可能性大。
理由:肺窗显示片影,纵隔窗未能显示具体结节,说明渗出成分为主。建议必要时薄层扫描观察。
2,胸膜病变,以胸膜间皮瘤可能性大。
3,患者做胃肠造影不超过2小时,还有其他不适?
作者: 小翟 时间: 2005-12-11 04:59
胸膜病变,以胸膜间皮瘤可能性大
作者: wwp 时间: 2005-12-11 05:31
支持:周围型肺ca并多发胸膜转移.胸膜间皮瘤不能除外.强化
作者: bhyl 时间: 2005-12-11 06:51
标题: 回复:ct2380:胸部病变,请讨论
以下是引用wwp在2005-12-10 21:31:00的发言:[br]支持:周围型肺ca并多发胸膜转移.胸膜间皮瘤不能除外.强化
作者: bhyl 时间: 2005-12-11 06:54
有没有石绵史?
作者: mingtian-5587 时间: 2005-12-11 07:57
左肺下叶基底段见结节样稍高密度影,内密度不均匀,边缘不清,可见索条影与邻近胸膜粘连,左侧胸膜上见多个结节影,以宽基底与胸膜粘连.纵隔不宽,内未见明确肿大的淋巴结.
考虑:周围型肺ca伴左侧胸膜转移可能性大 ,不完全除外左肺下叶炎性假瘤,左侧胸膜间皮瘤可能,建议强化ct扫描。
作者: jiangjing 时间: 2005-12-11 07:59
支持:周围型肺ca并多发胸膜转移.胸膜间皮瘤不能除外.建议强化
作者: lushijun 时间: 2005-12-11 16:09
支持胸膜间皮瘤
作者: huangaiying1 时间: 2005-12-11 16:58
支持胸膜间皮瘤
作者: leesen 时间: 2005-12-11 21:51
ct所见:左肺上、下叶近胸膜肺外带可见多个大小不等的结节灶,边界清楚,边缘比较光整。近胸膜病灶似与胸膜以宽基底紧连。提供的病史比较简单,我考虑:1、胸膜原发肿瘤可能性大(就形态来看恶性可能性不大);那么大胆的设想一下,左下叶结节是否与它有必然的联系呢?也可以是结核或周围型肺癌。2、还可以考虑为胸膜和肺内的都是转移灶,病人65岁,是不是其他部位的恶性肿瘤转移过来的呢?因为病灶比较表浅,但一侧发病较少见。3、周围型肺癌并胸膜转移的可能性比较小,一是肺内病灶较小,单发,胸膜结节相对较多,位置较远,临近胸膜无受侵。
以上愚见,望大家指正!!
作者: sun123456 时间: 2005-12-11 23:15
支持
作者: shibing 时间: 2015-5-31 13:29
周围型肺癌,
| 欢迎光临 医影在线 (http://bbs.radida.com/bbs/) |
Powered by Discuz! X3.2 |